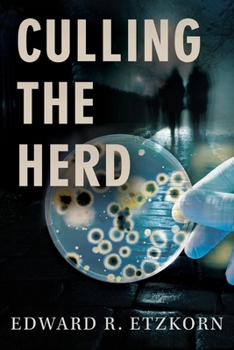
Paperback Culling the Herd: Volume 1 Book

Culling the Herd: Volume 1
While working for a humane organization in Kenya, Chloe Freestaff, a twentysomething magazine writer, finds evidence of a mass murder in a remote grassland. Infuriated by the senseless slaughter, she determines to find the perpetrators.Back home in New York, she learns of a secret group called Population Office for the World, whose five members, all scientists, believe that the only way to save the future earth from human-caused destruction is by reducing the world's population at any cost. When the entire population of San Ignacio, a small California city, is wiped out by an aerosolized toxin, Chloe is sure this group is responsible. She tracks down the group's leaders, but is captured and, in order to survive, agrees to write an article for them.The article, intended to convince the world to take population control seriously, will announce the date of the next strike but not its location--which will be Phoenix, Arizona. As disturbing as the strike itself is Chloe's discovery that the toxin originates from deep-sea corals, whose DNA is spliced into the genome of E. coli bacteria that, unlike the usual attenuated laboratory bacteria, can potentially share their genes with the E. coli that inhabit the bowels of every person on earth.Although she has come to agree with the group's message, if not its methods, her escape is now even more urgent, to save not just her own life, but that of the residents of Phoenix and possibly millions of other people as well.
Format:Paperback
Language:English
ISBN:1543924492
ISBN13:9781543924497
Release Date:April 2018
Publisher:Bookbaby
Length:330 Pages
Weight:1.15 lbs.
Dimensions:1.0" x 6.0" x 8.9"
Customer Reviews
0 rating